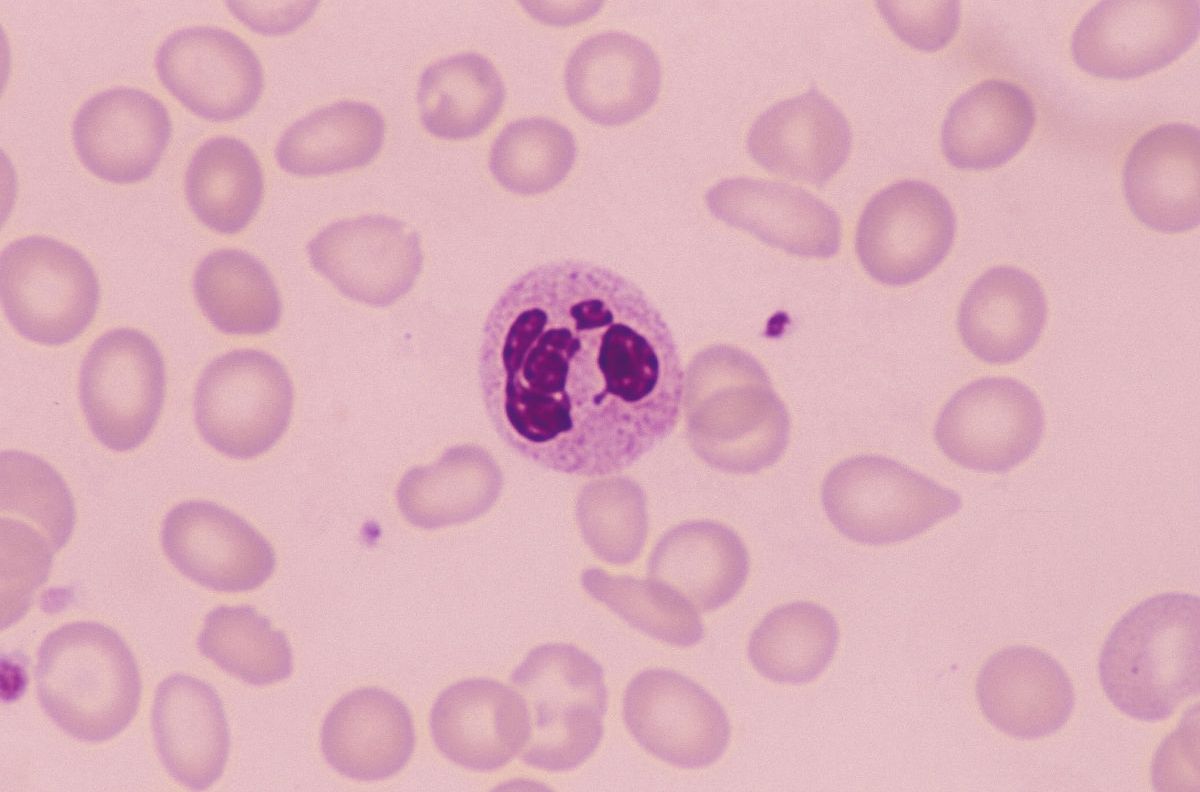
中性细胞数

中性晚幼粒细胞

中性晚幼粒细胞 05
图片尺寸650x484
中性晚幼粒细胞
图片尺寸545x480
中性晚幼粒细胞2017210请报告箭头所指对象的名称大血小板,巨血小板
图片尺寸811x633
实验诊断学 ←晚幼粒细胞
图片尺寸1080x810
实验诊断学 中性晚幼粒 细胞
图片尺寸1080x810
血常规检查中,若是这3个指标升高,或要做进一步诊断
图片尺寸1112x829
其它 基础细胞图片 写美篇答案:嗜酸性晚幼粒细胞 形态特征:胞体呈
图片尺寸1818x1818
其它 周四日常美图 写美篇答案:巨中性中幼粒细胞 形态特征:胞体较大
图片尺寸1225x918
看图识细胞(第45期)_颗粒
图片尺寸1018x974
中性中幼粒细胞
图片尺寸545x480
中性中幼粒细胞 04
图片尺寸650x484
▼「晚幼红细胞」形态特征:细胞胞体呈圆形或类圆形;胞浆量较多,与
图片尺寸1080x886
中性中幼粒
图片尺寸640x484
1.中性晚幼粒 2.中性中幼粒嗜酸性晚幼粒胞体:此处没什么值得说.
图片尺寸960x727
儿童中性粒细胞百分比偏低是什么原因导致的
图片尺寸941x941
中性细胞数
图片尺寸1200x792
中幼粒,杆状,晚幼.jpg
图片尺寸1280x960
粒 细 胞 系 列 原粒 早幼粒 中幼粒 晚幼粒 杆状核粒 分叶核粒
图片尺寸1080x810
中性粒细胞
图片尺寸685x1023
晚幼红细胞
图片尺寸640x493